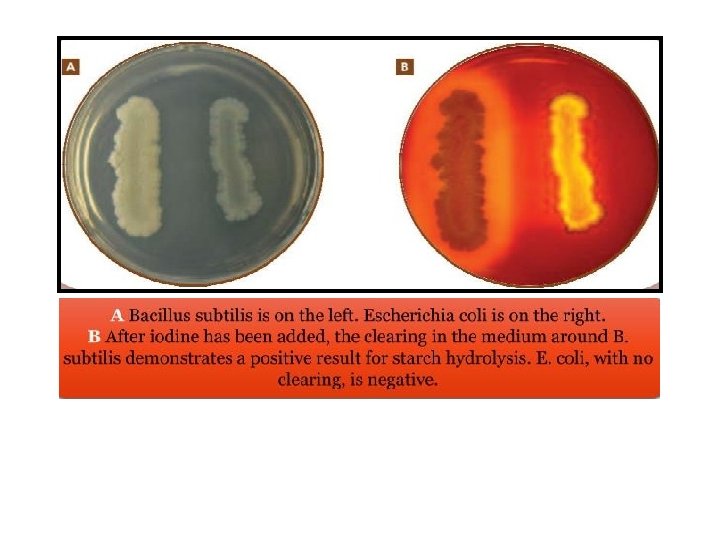

Biochemical Tests Medical Microbiology Lab 6 Oxidase Test

Biochemical Tests Medical Microbiology Lab. 6

Oxidase Test q Also known as the cytochrome oxidase Test q Oxidase enzymes play an important role in the operation of the electron transport system during aerobic respiration. q Cytochrome oxaidase uses O 2 as an electron acceptor during the oxidation of reduced cytochrome to form water and oxidized cytochrome. q The oxidase test is for determining the production of cytochrome c oxidases by a bacteria. q You can differentiate bacteria species as aerobes and anaerobes.

q This test is a useful procedure in clinical laboratory because of some gram negative pathogenic bacteria are oxidase positive (Pseudomonas aeruginosa and Neisseria spp. ) Enterobacteriaceae family are oxidase negative. Procedure q Put loopful of bacteria on oxidase test paper - redox indicator. q Observe the color. q Oxidase reagent(1%solution of dimethyl - p – phenylene - diaminehydrochlorid). q The reagent turns (dark blue to purple) when oxidized (oxidase - positive ) the reagent is colorless when reduced (oxidase – negative).

Swab method Direct plate method Filer paper method

Catalase test Catalase production Enzyme name catalase Substrate name hydrogen peroxide Enzyme action breakdown the toxic H 2 O 2 producing oxygen gas and water 2 H 2 O 2 -------► 2 H 2 O + O 2↑ Catalase Hydrogen peroxide produce due to the aerobic respiration of the cells and have to be breakdown to prevent it’s toxic action on DNA and cell membrane


Coagulase Test q. Coagulase test is one of the biochemical tests. q. It is very important test in the microbiology. q. The coagulase test identifies whether an organism produces the exoenzyme coagulase, which causes the fibrin of blood plasma to clot. q. Organisms that produce Coagulase can form protective barriers of fibrin around themselves, making themselves highly resistant to phagocytosis, other immune responses, and some other antimicrobial agents.

Tube method Slide method

Gelatin hydrolysis q. Certain bacteria are able to hydrolyze gelatin by secreting a proteolytic enzyme called gelatinase. q. The resulting amino acids can then be used as a nutrients by the bacteria. q. The ability of some bacteria to digest gelatin is an important characteristic in their differentiation. q. Gelatin liquefaction can be tested by stabbing nutrient gelatin deep tubes following incubation , the cultures are placed in refrigerator at 4 C˚ until the bottom are solidifies.

q. If gelatin has been hydrolyzed , the medium will remain liquid after refrigeration. q. If gelatin has not been hydrolyzed , the medium will be solidfy during the time it is in refrigerator

Proteus vulgaris Escherichia coli

Urease hydrolysis q. Urease activity (the urease test) is detected by growing bacteria in medium containing urea and using a p. H indicator such as phenol red. q. When urea is hydrolyzed, ammonia accumulates in the medium and makes it alkaline. q This increase in p. H causes the indicator to change from orange-red to deep pink or purplish red and is a positive test for urea hydrolysis. q. This test is particularly useful in distinguishing the genus Proteus from other enteric bacteria


Starch hydrolysis

- Slides: 16